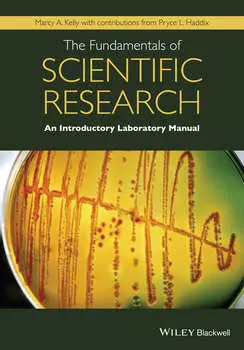
The Fundamentals of Scientific Research

-
 None199 ₽
None199 ₽N?r og hvorfor dukket mennesket opp? | I l?pet av de siste 20 ?rene har medlemmer av Zoonomia international consortium dechiffrert genomene til dyr fra forskjellige familier og sammenlignet dem med se...
-
 None279 ₽
None279 ₽Биология добра и зла. Как наука объясняет наши поступки. Роберт Сапольски. Саммари | Это саммари – сокращенная версия книги «Биология добра и зла. Как наука объясняет наши поступки» Роберта Сапольски....
-
 None16892 ₽
None16892 ₽Protein Conformation | How the amino acid sequence of a protein determines its three-dimensional structure is a major problem in biology and chemistry. Leading experts in the fields of NMR spectroscop...
-
 None990 ₽
None990 ₽Флора и фауна Белого моря | Иллюстрированный атлас морских обитателей Белого моря включает цветные фотографии и описания 285 видов морских растений, беспозвоночных и позвоночных животных, позволяющие ...
-
 None499 ₽
None499 ₽Термодинамика комплексообразования лигандов с нуклеиновыми кислотами в водном растворе | Монография посвящена термодинамическому анализу реакций нековалентного комплексообразования биологически активн...
-
 None1118 ₽
None1118 ₽Звери России | Настоящее учебное пособие подготовлено в помощь студентам биологического факультета, обучающимся по направлению подготовки «Биология» специализация «Охотоведение» и «Биоэкология» для из...
-
 None550 ₽
None550 ₽Двенадцать: от грызунов до кабанов | Книга адресована всем, кто интересуется животным миром. Содержит двенадцать глав о зверях и птицах, отражённых в Восточном календаре. Помимо биологии и мест обитан...
-
 None99 ₽
None99 ₽Гузель, или Двойное слово пацана | Я проводил ревизию старых вещей в гараже с целью выбросить некоторые из них по причине полной ненадобности. Как любопытствующий археолог, я увлекся процессом и посте...
-
![Светозависимый биосинтез хлорофилла]() None319 ₽
None319 ₽Светозависимый биосинтез хлорофилла | В книге последовательно рассматриваются этапы заключительного этапа биосинтеза хлорофилла от формирования активного протохлорофиллид-ферментного комплекса до путе...
-
![ОГЭ-2026. Биология. Тематические тренировочные задания]() None209 ₽
None209 ₽ОГЭ-2026. Биология. Тематические тренировочные задания | Книга предназначена для подготовки учащихся к ОГЭ по биологии. Пособие содержит задания разного уровня сложности по основным темам курса, знани...
-
![Landscape Genetics]() None6827 ₽
None6827 ₽Landscape Genetics | Despite the substantial interest in landscape genetics from the scientific community, learning about the concepts and methods underlying the field remains very challenging. The re...
-
![Разведение верблюдов в Подмосковье. Монография]() None60 ₽
None60 ₽Разведение верблюдов в Подмосковье. Монография | Книга посвящена верблюдоводству – малоизученной отрасли животноводства в России. Авторы раскрывают секреты разведения верблюдов в Московской области, ч...
-
![Physiology of Salt Stress in Plants]() None17977 ₽
None17977 ₽Physiology of Salt Stress in Plants | PHYSIOLOGY OF SALT STRESS IN PLANTS Discover how soil salinity affects plants and other organisms and the techniques used to remedy the issue In Physiology of Sal...
-
![Биология. Концентрический курс. 8 класс]() None500 ₽
None500 ₽Биология. Концентрический курс. 8 класс | Учебник содержит материал по разделу курса биологии «Человек и его здоровье» и рассчитан на изучение предмета 2 ч в неделю. Учебник включает лабораторные и пр...
-
![Река, выходящая из Эдема. Жизнь с точки зрения дарвиниста]() None399 ₽
None399 ₽Река, выходящая из Эдема. Жизнь с точки зрения дарвиниста | Если на улице вам вдруг повстречается человек, никогда ничего не слышавший о Ричарде Докинзе, вы можете смело советовать этому чудаку «Реку,...
-
![Principles of Virology, Volume 1]() None9666 ₽
None9666 ₽Principles of Virology, Volume 1 | PDF. Категория: знания и навыки/учебная и научная литература/естественные науки/биология/общая биология
-
![Молекулярная биология]() None170 ₽
None170 ₽Молекулярная биология | В практикуме представлены материалы для студентов по освоению учебной дисциплины «Молекулярная биология». Учебный материал структурирован по темам. По каждой теме кратко обозна...
-
![Основы нейробиологии]() None576 ₽
None576 ₽Основы нейробиологии | Содержит полное и систематическое изложение материала, входящего в учебную программу курса «Нейробиология», изучаемую студентами специальности «Биология» Академии биологии и био...
-
![Общая биология. Пособие для старшеклассников и поступающих в вузы]() None99 ₽
None99 ₽Общая биология. Пособие для старшеклассников и поступающих в вузы | Форматы: MP3,M4B. Фрагмент: https: //www.litres.ru/audiotrial/?art=71007577. Категория: знания и навыки/учебная и научная литература...
-
![Мифы об эволюции человека]() None399 ₽
None399 ₽Мифы об эволюции человека | Отрекся ли Чарльз Дарвин в конце жизни от своей теории эволюции человека? Застали ли древние люди динозавров? Правда ли, что Россия – колыбель человечества, и кто такой йет...
-
![Радиационная биология. (Бакалавриат, Специалитет). Учебник.]() None1430 ₽
None1430 ₽Радиационная биология. (Бакалавриат, Специалитет). Учебник. | Включает в себя основные разделы радиобиологии: понятие об ионизирующем излучении, строение атома, типы ядерных распадов, взаимодействие и...
-
![Биология]() None179 ₽
None179 ₽Биология | Издание адресовано учащимся 9-х классов для подготовки к ОГЭ по биологии и содержит задания, сгруппированные по видам проверяемых умений и способов действий. Приводится информация о каждом ...
-
![Методика обучения биологии]() None399 ₽
None399 ₽Методика обучения биологии | Учебно-методическое пособие содержит новые идеи, значимые для развития современного интегративного подхода в теории и практике обучения и решения проблемы формирования мет...
-
![Биология]() None599 ₽
None599 ₽Биология | Книга «Биология» из серии «Нескучная наука» очень увлекательна, содержит массу интересных фактов, написана живым языком. И в то же время даёт целостное, систематическое представление о совр...
-
![ЧУДЕСНЫЙ ВОРОХ. Птицы Восточного Оренбуржья]() None100 ₽
None100 ₽ЧУДЕСНЫЙ ВОРОХ. Птицы Восточного Оренбуржья | Степи и лесостепи Оренбургской области зимой выглядят пустынными. Но это не так. Здесь не прекращается жизнь. И заметнее всего она проявляется у птиц. Осо...
-
![Bionik]() None932 ₽
None932 ₽Bionik | Dieser erste Band der Reihe gibt einen ?berblick ?ber die spannende und zukunftsorientierte Wissenschaft Bionik und ihre Anwendung. Er zeigt, wie die lebende Natur als L?sungsquelle f?r techn...
-
![Анатомия жива! Удивительные и важные медицинские открытия XX-XXI веков, которые остались незамеченными]() None409 ₽
None409 ₽Анатомия жива! Удивительные и важные медицинские открытия XX-XXI веков, которые остались незамеченными | Эта книга доказывает: за сухими строчками из учебника биологии скрываются захватывающие истории...
-
![ЕГЭ-2018. Биология. 10 тренировочных вариантов экзаменационных работ для подготовки к единому государственному экзамену]() None199 ₽
None199 ₽ЕГЭ-2018. Биология. 10 тренировочных вариантов экзаменационных работ для подготовки к единому государственному экзамену | Вниманию школьников и абитуриентов предлагается пособие для подготовки к ЕГЭ, ...
-
![Working in Biosafety Level 3 and 4 Laboratories]() None10125 ₽
None10125 ₽Working in Biosafety Level 3 and 4 Laboratories | The first training manual for new staff working in BSL3/4 labs. This guide is based on a course developed in 2007 by the EU COST action group 28b whic...
-
![Recent Advances in Polyphenol Research, Volume 7]() None17720 ₽
None17720 ₽Recent Advances in Polyphenol Research, Volume 7 | PDF. Категория: знания и навыки/учебная и научная литература/естественные науки/биология/общая биология
-
![Микробиология для медицинских специальностей и еПриложение. (Бакалавриат, Специалитет). Учебник.]() None1300 ₽
None1300 ₽Микробиология для медицинских специальностей и еПриложение. (Бакалавриат, Специалитет). Учебник. | Включает два раздела. Раздел I «Сопутствующие дисциплины клинической микробиологии» состоит из 10 гла...
-
![The Fundamentals of Scientific Research]() None4984 ₽
None4984 ₽The Fundamentals of Scientific Research | The Fundamentals of Scientific Research: An Introductory Laboratory Manual is a laboratory manual geared towards first semester undergraduates enrolled in gen...
-
![Что такое РНК-мир?]() None199 ₽
None199 ₽Что такое РНК-мир? | В этой книге мы отправимся в увлекательное путешествие, где наука встречается с философией, а биология с квантовой физикой. Вы узнаете, как РНК не только является «инструментом» ж...
-
![The Explosion of Life Forms]() None15804 ₽
None15804 ₽The Explosion of Life Forms | One of the essential characteristics of living beings is the explosion of variety in their forms that is intrinsically linked to the diversity of the environments they ha...
-
![Culture of Animal Cells]() None9957 ₽
None9957 ₽Culture of Animal Cells | Since the publication of the sixth edition of this benchmark text, numerous advances in the field have been made – particularly in stem cells, 3D culture, scale-up, STR profi...
-
![Наука подтверждает – 9. Сборник статей]() None240 ₽
None240 ₽Наука подтверждает – 9. Сборник статей | Ученые экспериментально доказали, что молекулы транспортной РНК могли стать главным элементом в эволюции ранних форм жизни. Лошади в современном виде впервые п...
-
![On the Origin of Species]() None299 ₽
None299 ₽On the Origin of Species | On the Origin of Species first appeared in 1859, and it remains a continuing source of conflict to this day. Even among those who reject its ideas, however, the work's impac...
-
![Доклады МОИП. Секция Геронтологии. Том 67]() None100 ₽
None100 ₽Доклады МОИП. Секция Геронтологии. Том 67 | В сборнике представлены научные статьи авторов на основе докладов, прочитанных на заседаниях Секции Геронтологии МОИП за 2019—2020 гг. Работы посвящены теор...
-
![Рабочая программа к учеб. Исаевой Романовой Биология 6 кл. 1 час в нед. (мИннШк) Новикова]() None275 ₽229 ₽-16%
None275 ₽229 ₽-16%Рабочая программа к учеб. Исаевой Романовой Биология 6 кл. 1 час в нед. (мИннШк) Новикова | Рабочая программа соответствует требованиям Федерального государственного стандарта общего образования по би...
-
![Биология. 8 класс. Технологические карты уроков по учебнику Д. В. Колесова, Р. Д. Маша, И. Н. Беляева]() None742 ₽610 ₽-17%
None742 ₽610 ₽-17%Биология. 8 класс. Технологические карты уроков по учебнику Д. В. Колесова, Р. Д. Маша, И. Н. Беляева | В пособии представлены технологические карты уроков биологии для 8 класса, разработанные в соотв...
-
![Биология. 10-11 классы. Базовый уровень. Учебник для общеобразовательных организаций. В двух частях. Часть 2. Учебник для детей с нарушением зрения]() None3303 ₽2715 ₽-17%
None3303 ₽2715 ₽-17%Биология. 10-11 классы. Базовый уровень. Учебник для общеобразовательных организаций. В двух частях. Часть 2. Учебник для детей с нарушением зрения | Учебник предназначен для детей с нарушением зрения...
-
![Шпаргалка по биологии для успешной сдачи ОГЭ и ЕГЭ]() None107 ₽89 ₽-16%
None107 ₽89 ₽-16%Шпаргалка по биологии для успешной сдачи ОГЭ и ЕГЭ | Краткий курс по биологии поможет школьнику подготовиться к экзамену ЕГЭ и ОГЭ. Повторить пройденный материал, закрепить полученные знания. None. Ка...
-
![Биология. 9 класс. Рабочая программа по учебнику М.Р. Сапина, Н.И. Сонина к УМК "Живой организм"]() None251 ₽209 ₽-16%
None251 ₽209 ₽-16%Биология. 9 класс. Рабочая программа по учебнику М.Р. Сапина, Н.И. Сонина к УМК "Живой организм" | В пособии представлена рабочая программа по биологии для 9 класса (линейный курс), разработанная в со...
-
![Биология. Учебник. 8 класс. В 2-х частях. ФГОС (комплект)]() None1120 ₽921 ₽-17%
None1120 ₽921 ₽-17%Биология. Учебник. 8 класс. В 2-х частях. ФГОС (комплект) | Учебник в печатной и электронной формах входит в состав завершенной предметной линии по биологии издательства "Академкнига/Учебник". Учебник...
-
![Биология. 7 класс. Рабочая тетрадь №2]() None707 ₽581 ₽-17%
None707 ₽581 ₽-17%Биология. 7 класс. Рабочая тетрадь №2 | В тетради представлена система заданий, выстроенная в логике учебника «Биология. 7 класс» (авторы: Т.С. Сухова, С.П. Шаталова) и позволяющая организовать индиви...
-
![Биология. 9 класс Технологические карты уроков по учебнику М. Р. Сапина Н. И. Сонина УМК Живой орган]() None1096 ₽901 ₽-17%
None1096 ₽901 ₽-17%Биология. 9 класс Технологические карты уроков по учебнику М. Р. Сапина Н. И. Сонина УМК Живой орган | В пособии представлены технологические карты уроков по биологии для 9 класса, разработанные в соо...
-
![ЕГЭ и ОГЭ Биология Раздел Животные 500 заданий… (2 изд) (мЕГЭиОГЭ) Кириленко]() None412 ₽339 ₽-17%
None412 ₽339 ₽-17%ЕГЭ и ОГЭ Биология Раздел Животные 500 заданий… (2 изд) (мЕГЭиОГЭ) Кириленко | Пособие посвящено разделу биологии «Животные». Книга содержит: .-теоретический материал, оформленный в наглядных схемах, ...
-
![Занимательная биология]() None683 ₽562 ₽-17%
None683 ₽562 ₽-17%Занимательная биология | Книга советского биолога, писателя и популяризатора науки для детей Игоря Акимушкина "Занимательная биология" расскажет о том, как образовалась наша планета и как на ней зарод...
-
![Зоология. Учебник для 6-7 классов средней школы]() None1037 ₽853 ₽-17%
None1037 ₽853 ₽-17%Зоология. Учебник для 6-7 классов средней школы | Почему белую бабочку, летающую над огородом летом, называют капустницей? Из-за чего у всех птиц повышенная температура — в среднем, 42°С? Может ли лев...
-
![Открытые задачи. Биология. Сильное мышление через открытые задачи]() None1297 ₽1066 ₽-17%
None1297 ₽1066 ₽-17%Открытые задачи. Биология. Сильное мышление через открытые задачи | В книге 250 необычных открытых задач для продуктивного развития ума. Все задачи удивляют, тренируют навыки изобретательского и иссле...
-
![Занимательная биология]() None1061 ₽872 ₽-17%
None1061 ₽872 ₽-17%Занимательная биология | "Занимательная биология" серии "Моя первая книга" познакомит юных читателей с основами биологии, которую им предстоит изучать в школе. .Дети узнают о "живом" и "неживом", о ви...
-
![Биология. 6 класс. Учебное пособие. В 2 частях. Часть 1 (для слабовидящих обучающихся)]() None7787 ₽6401 ₽-17%
None7787 ₽6401 ₽-17%Биология. 6 класс. Учебное пособие. В 2 частях. Часть 1 (для слабовидящих обучающихся) | Учебное пособие предназначено для детей с нарушением зрения. Данное издание подготовлено в соответствии с содер...
-
![Занимательная биология]() None1887 ₽1551 ₽-17%
None1887 ₽1551 ₽-17%Занимательная биология | «Занимательная биология» серии «Моя первая книга» познакомит юных читателей с основами биологии, которую им предстоит изучать в школе. Дети узнают о «живом» и «неживом», о вир...
-
![Увлекательно о биологии: в иллюстрациях]() None1710 ₽1406 ₽-17%
None1710 ₽1406 ₽-17%Увлекательно о биологии: в иллюстрациях | В книге Андрея Шляхова - увлекательная, но тем не менее проверенная и важная информация о нашем мире и всех проявлениях жизни в нем. Появление жизни на Земле,...
-
![Биология. 7 класс. Рабочая тетрадь №1]() None707 ₽581 ₽-17%
None707 ₽581 ₽-17%Биология. 7 класс. Рабочая тетрадь №1 | В тетради представлена система заданий, выстроенная в логике учебника «Биология. 7 класс» (авторы: Т.С. Сухова, С.П. Шаталова) и позволяющая организовать индиви...
-
![Биология. 7-8 классы. Материалы к урокам. Зоологический калейдоскоп: рыбы, земноводные, пресмыкающиеся. ФГОС]() None239 ₽199 ₽-16%
None239 ₽199 ₽-16%Биология. 7-8 классы. Материалы к урокам. Зоологический калейдоскоп: рыбы, земноводные, пресмыкающиеся. ФГОС | Пособие содержит задания и материалы к урокам биологии по разделам "Надкласс Рыбы", "Клас...
-
![Биология. 6 класс. Базовый уровень. Учебное пособие. В двух частях. Часть 2 (для слабовидящих обучающихся)]() None7787 ₽6401 ₽-17%
None7787 ₽6401 ₽-17%Биология. 6 класс. Базовый уровень. Учебное пособие. В двух частях. Часть 2 (для слабовидящих обучающихся) | Учебное пособие предназначено для детей с нарушением зрения. Данное издание подготовлено в ...
-
![Учебник по биологии ЕГЭ, ОГЭ]() None2595 ₽2133 ₽-17%
None2595 ₽2133 ₽-17%Учебник по биологии ЕГЭ, ОГЭ | Учебник для подготовки к ЕГЭ и ОГЭ по биологии 2025 - забудь про зубрёжку и перестань учить лишнее! В учебнике исключительно самая актуальная информация, которая будет н...
-
![Биология добра и зла. Как наука объясняет наши поступки. Часть 1,2 (комплект из 2 книг)]() None1651 ₽1357 ₽-17%
None1651 ₽1357 ₽-17%Биология добра и зла. Как наука объясняет наши поступки. Часть 1,2 (комплект из 2 книг) | Как говорит знаменитый приматолог и нейробиолог Роберт Сапольски, если вы хотите понять поведение человека и п...
-
![Организмы, виды и эволюция / Изд. стереотип.]() 599 ₽
599 ₽Организмы, виды и эволюция / Изд. стереотип. | В настоящей книге приводится краткий обзор основ современной эволюционной теории, при этом особенное внимание уделено обусловленности различных форм и ме...
-
![Трансформационная типологическая систематика]() None215 ₽179 ₽-16%
None215 ₽179 ₽-16%Трансформационная типологическая систематика | В книге обсуждаются теоретические основы биологической классификации. В ней нет готовых ответов. Ее роль, скорее, в постановке вопросов и обозначении пут...
-
![Тесты по биологии. 7 класс: к учебнику Н. Сонина, В. Захарова "Биология. Многообразие живых организмов. 7 класс". 3 -е изд. ФГОС (к новому учебнику)]() None239 ₽199 ₽-16%
None239 ₽199 ₽-16%Тесты по биологии. 7 класс: к учебнику Н. Сонина, В. Захарова "Биология. Многообразие живых организмов. 7 класс". 3 -е изд. ФГОС (к новому учебнику) | Данное пособие полностью соответствует федерально...
-
![Биология. 7 класс. Базовый уровень. Рабочая тетрадь]() None742 ₽610 ₽-17%
None742 ₽610 ₽-17%Биология. 7 класс. Базовый уровень. Рабочая тетрадь | Рабочая тетрадь является составной частью учебно-методического комплекта серии «Линия жизни» для 7 класса под редакцией В. В. Пасечника и адресова...
-
![Биология. Решение задач по генетике]() None1037 ₽853 ₽-17%
None1037 ₽853 ₽-17%Биология. Решение задач по генетике | В учебном пособии, написанном преподавателем биологического факультета МГУ имени М. В. Ломоносова, около 120 задач по генетике. Материал распределен по главам. В ...
Учебники по биологии
В категории "учебники по биологии" найдено товаров: 5635 | Страница 29